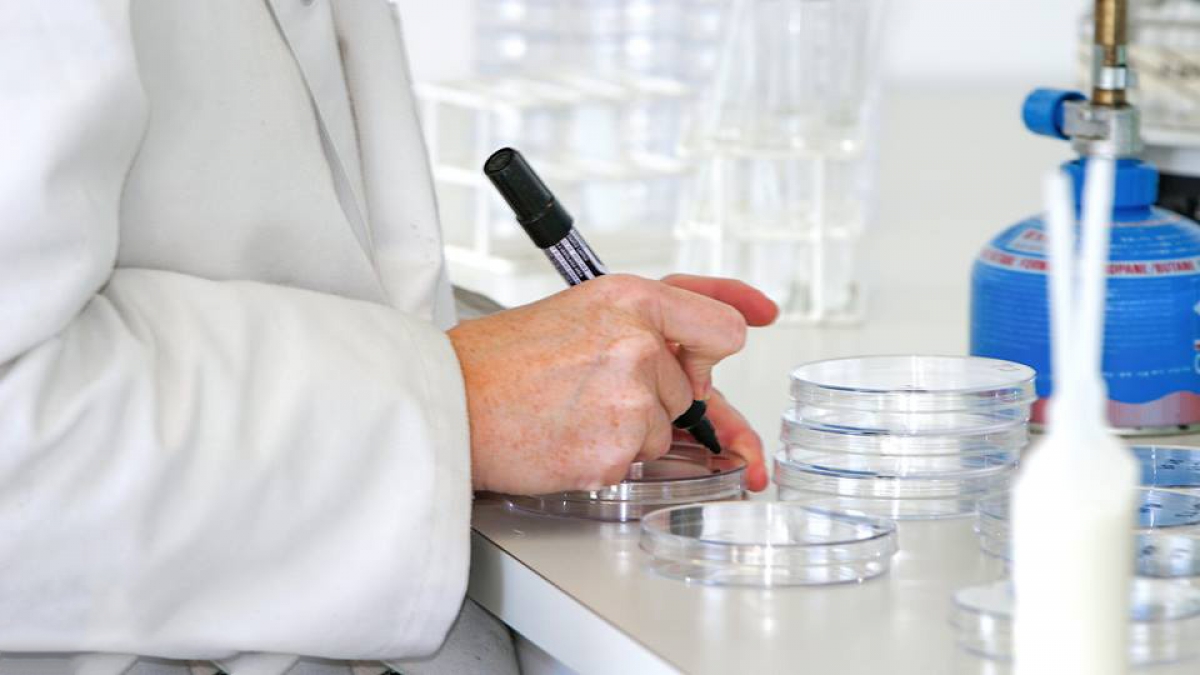

Unemployment
05. Jan 2021
Unemployment rate in October was 1.3%
The graph below shows the unemployment rate and the trend. The semi-transparent line represents the unemployment rate, and the solid line shows the trend.
In October, the unemployment rate was 1.3% (383 full-time unemployed people). In October 2019, this rate was 0.9%.
[px-graph-1]
In October, 1.2% of the male and 1.5% of the female labour force were unemployed. In October 2019, these figures were 0.8% and 0.9%, respectively.
[px-graph-2]
The map below shows the unemployment rates in each region. In October, Vágar had the highest unemployment rate at 2.1%, and Norðoyggjar had the lowest at 0.7%,
[px-graph-3]
In October, 12.5% of the unemployed people had been out of work for more than a year, compared to 15.9% in October 2019.
[px-graph-4]
Why is there a two-month lag in the figures?
Many delayed entries are filed after the end of the registered month. A two-month lag helps ensure accuracy in the statistics.
About unemployment
An unemployed person is defined as someone without a job, fully available to the job market and actively seeking work, aged between 16 and 66 and registered as unemployed in the Faroese unemployment system and the social services in accordance with the above conditions.
Two categories are used in unemployment statistics: full-time unemployment and affected by unemployment.
Affected by unemployment: The number of people who have been unemployed for one or more days in a month.
Full-time unemployment: Since not everyone is unemployed every day of a given month, all individuals affected by unemployment are converted to full-time unemployed. For example, a person who has been unemployed for half a month counts as 0.5 full-time unemployed.
Unemployment rate: The full-time unemployment rate relative to the size of the labour force.
About the trend
The trend describes the unemployment trend by adjusting for seasonal effects and error components in the figures.